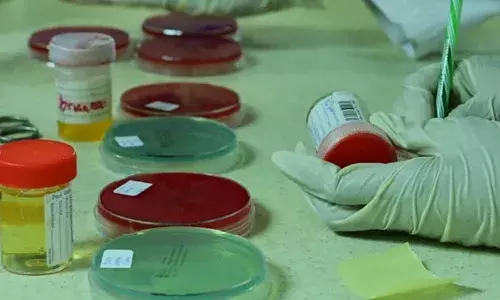
भारतीय संसद ने पारित किया राष्ट्रीय डोपिंग-रोधी विधेयक

Begin typing your search above and press return to search.
- BWF World Junior C’ships 2025: भारत ने कोरिया को हराकर सुनिश्चित किया...
- नवी मुंबई में होने जा रही महाराष्ट्र की पहली फॉर्मूला नाइट स्ट्रीट रेस
- दुबई में हुआ इंडियन रोल बॉल लीग का भव्य अंतरराष्ट्रीय शुभारंभ
- बैजलपुर हरियाणा में गैलेंट स्पोर्ट्स ने बनाया विश्वस्तरीय हॉकी ग्राउंड
- 64वां सुब्रोतो कप नई दिल्ली में शुरू
- 64वां सुब्रतो कप 19 अगस्त से होगा शुरू, 106 टीमें मैदान में उतरेंगी
- Asian U20 Championships: भारत ने अंतिम दिन दो स्वर्ण जीते, तीसरे स्थान...
- मैग्नस कार्लसन, डिंग लिरेन, विश्वनाथन आनंद, इयान नेपोमनियात्ची और कई...
- प्रो पंजा लीग के उद्घाटन संस्करण के लिए नई दिल्ली में जुटेंगे आर्म...
- ISSF Junior World Cup: भारतीय निशानेबाजों ने दो और स्वर्ण पदक जीते